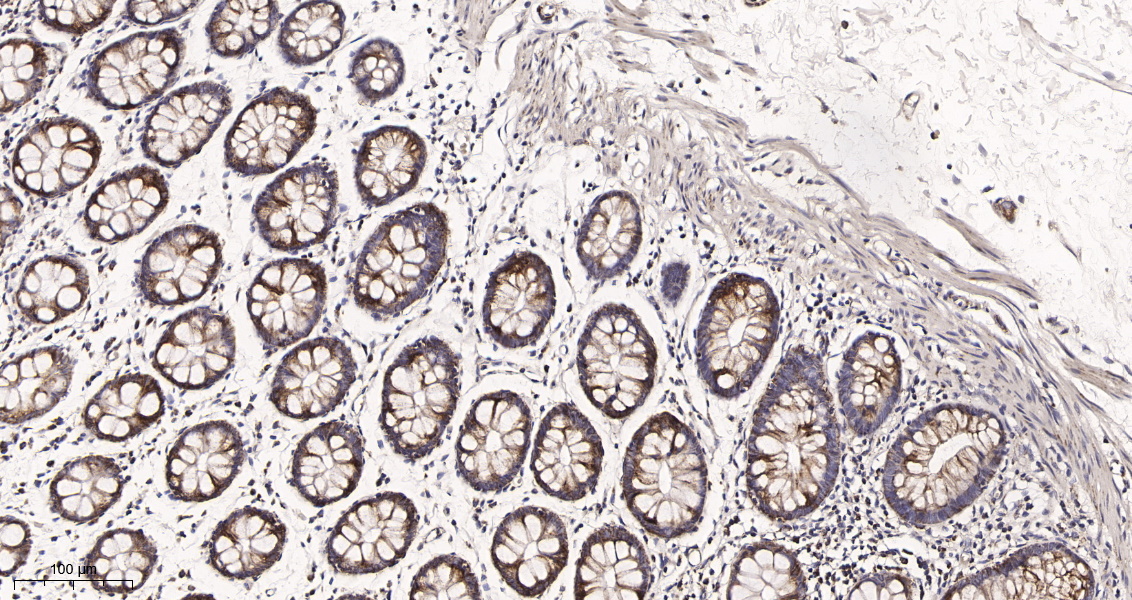

- 生化试剂
- ELISA检测
-
抗体蛋白
二抗生物素标记 过氧化物酶(HRP)标记 胶体金试剂 FITC荧光标记 RBITC荧光标记 二抗免疫血清 其它荧光标记二抗 藻红蛋白(PE)荧光标记 胶体金(Gold)标记 SAlexa Fluor荧光系列 碱性磷酸酶(AP)标记 别藻蓝蛋白(APC)荧光标记 其它标记 PE标记二抗 DyLight标记二抗 AU标记二抗 Biotin标记二抗 AMCA标记二抗 Texas Red标记二抗 TRITC标记二抗 HRP标记二抗 未标记二抗 Cy标记二抗 AbBox Fluor标记二抗内参抗体 小分子抗体抗体标记试剂盒细菌抗体蛋白病毒包装试剂杂交瘤融合筛选WB、IHC、ELISA相关试剂细胞培养试剂病原微生物抗原抗体假病毒抗体校准品其他抗原抗体标记的标签抗体病理级IHC抗体重组蛋白
- 细胞培养
- 实验耗材
- 仪器设备
- 生化试剂盒
- 小分子试剂
- 基质胶
-
斑马鱼产品
订货时间:周一至周五
订货Q Q:79688691
订货邮件:79688691@qq.com
产品简介-
产品货号IM68903
-
产品名称UQCRC2 (15Z1) Rabbit Monoclonal Antibody
-
类别抗体产品
-
基因名称UQCRC2
-
蛋白名称Cytochrome b-c1 complex subunit 2, mitochondrial (Complex III subunit 2) (Core protein II) (Ubiquinol-cytochrome-c reductase complex core protein 2)
-
ClonalityMonoclonal
-
推荐应用WB,IHC-P,IF-P,IF-F,IF-ICC,IP,ELISA
-
反应种属Human,Mouse,Rat
-
存储缓冲液PBS, 50% glycerol, 0.05% Proclin 300, 0.05%BSA
-
Human Gene ID7385
-
Human Swissprot No.P22695
-
Mouse Gene ID67003
-
Mouse Swissprot No.Q9DB77
-
Rat Gene ID293448
-
Rat Swissprot No.P32551
-
稀释度IHC-P 1:200-1000,WB 1:1000-5000,IF-P/IF-F/IF-ICC 1:200-1000,ELISA 1:5000-20000,IP 1:50-200
-
参考分子量48kDa
-
预测分子量48kDa
-
宿主Rabbit
-
同种型Monoclonal, rabbit, IgG, Kappa
-
功能Component of the ubiquinol-cytochrome c oxidoreductase, a multisubunit transmembrane complex that is part of the mitochondrial electron transport chain which drives oxidative phosphorylation. The respiratory chain contains 3 multisubunit complexes succinate dehydrogenase (complex II, CII), ubiquinol-cytochrome c oxidoreductase (cytochrome b-c1 complex, complex III, CIII) and cytochrome c oxidase (complex IV, CIV), that cooperate to transfer electrons derived from NADH and succinate to molecular oxygen, creating an electrochemical gradient over the inner membrane that drives transmembrane transport and the ATP synthase. The cytochrome b-c1 complex catalyzes electron transfer from ubiquinol to cytochrome c, linking this redox reaction to translocation of protons across the mitochondrial inner membrane, with protons being carried across the membrane as hydrogens on the quinol. In the process called Q cycle, 2 protons are consumed from the matrix, 4 protons are released into the intermembrane space and 2 electrons are passed to cytochrome c (By similarity). The 2 core subunits UQCRC1/QCR1 and UQCRC2/QCR2 are homologous to the 2 mitochondrial-processing peptidase (MPP) subunits beta-MPP and alpha-MPP respectively, and they seem to have preserved their MPP processing properties (By similarity). May be involved in the in situ processing of UQCRFS1 into the mature Rieske protein and its mitochondrial targeting sequence (MTS)/subunit 9 when incorporated into complex III (Probable).
-
纯化Protein A
储存与保存1.保存:-20℃
2.有效期:1年
注意事项1.我司生产的生化试剂如无特殊标注,基本为非无菌包装,若用于细胞实验,请提前做好预处理。需低温保存的产品,一旦配成溶液,请分装保存,避免反复冻融造成的产品失效。
2.本产品仅供科研使用。请勿用于医药、临床诊断或治疗,食品及化妆品等用途。请勿存放于普通住宅区。
3.为了您的安全和健康,请穿好实验服并佩戴一次性手套和口罩操作。
4.实验结果可由多种因素影响,相关处理只限于产品本身,不涉及其他赔偿。
备注:由于产品信息可能会有优化升级,请以实际收货标签信息为准。